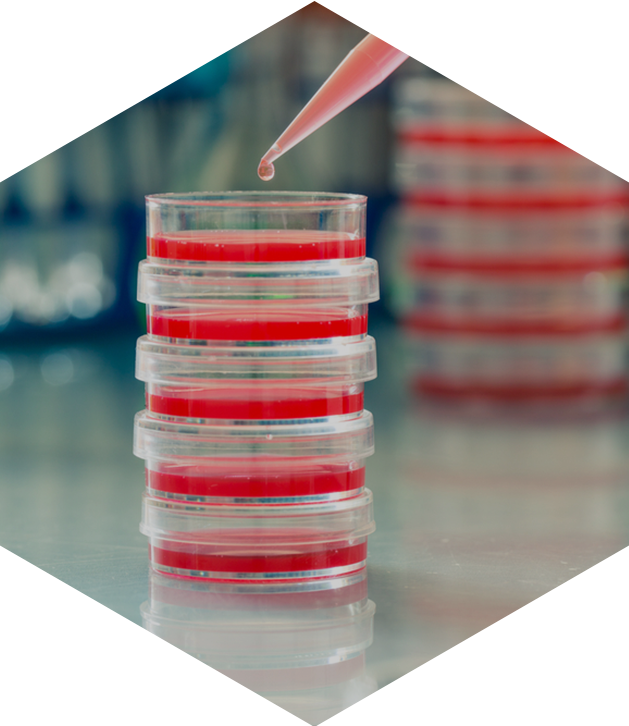

polymer analysis
Life Science Polymer Testing
Introduction
Lorem Ipsum is simply dummy text of the printing and typesetting industry. Lorem Ipsum has been the
industry's standard dummy
text ever since the 1500s, when an unknown printer took a galley of type
and scrambled it to make a type specimen book.
Life Science Polymer Testing
Lorem Ipsum is simply dummy text of the printing and typesetting industry. Lorem Ipsum has been the industry's standard dummy text ever since the 1500s, when an unknown printer took a galley of type and scrambled it to make a type specimen book. It has survived not only five centuries,
Examples of challenges include:
- polymer solubility
- ionic charge
- complex polymer chain microstructure
- very high molecular weight
- broad molecular weight distribution
- polymer aggregation
- polymer degradation, shelf-life, and stability
- oligomeric composition
- copolymer composition
- complex multi-component composition of final
- unknown concentration of the target polymer
- interference of other components with the

Life Science Polymer Testing
Lorem Ipsum is simply dummy text of the printing and typesetting industry. Lorem Ipsum has been the industry's standard dummy text ever since the 1500s, when an unknown printer took a galley of type and scrambled it to make a type specimen book. It has survived not only five centuries,
Examples of challenges include:
- polymer solubility
- ionic charge
- complex polymer chain microstructure
- very high molecular weight
- broad molecular weight distribution
- polymer aggregation
- polymer degradation, shelf-life, and stability
- oligomeric composition
- copolymer composition
- complex multi-component composition of final
- unknown concentration of the target polymer
- interference of other components with the
 CLICK TO CALL
CLICK TO CALL





